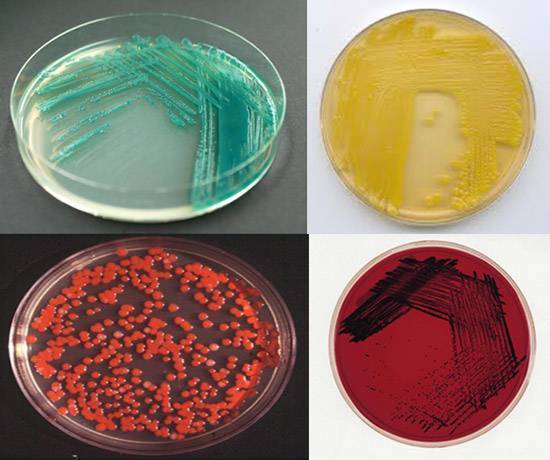
Размножаются бактерии путем деления и делают это очень быстро
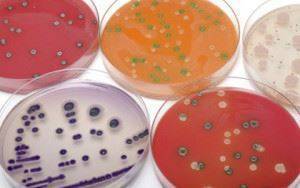
Размножаются бактерии путем деления и делают это очень быстро

С чего все начинается
Рост и размножение клетки – это два различных процесса. Под ростом понимают увеличение массы клетки вследствие формирования всех клеточных структур. Размножение – это увеличение количества клеток в колонии. Различают бинарное деление, почкование и генетическую рекомбинацию (процесс, напоминающий половое размножение).
Большинство прокариотических (безъядерных) клеток, к которым принадлежат все бактерии, размножается путем разделения надвое (бинарное деление). Таким способом размножаются, например, молочнокислые бактерии. Процесс начинается с удвоения бактериальной хромосомы (молекула ДНК, заменяющая ядро) и протекает в несколько этапов:
- клетка удлиняется;
- наружная оболочка «врастает» внутрь и образует поперечную перегородку (перетяжку);
- две новые (дочерние) клетки расходятся в разные стороны.
В результате получаются два идентичных организма.
Отдельные микроорганизмы делятся почкованием, но это скорее исключение из общего правила. Процесс заключается в образовании на одном из полюсов клетки короткого выступа, в который «дрейфует» одна из половин разделившегося нуклеоида (молекулы ДНК с генетической информацией). Затем выступ разрастается и отделяется от материнской клетки.
Есть еще вариант, напоминающий половое размножение, – генетическая рекомбинация. В этом случает происходит обмен генетической информацией и в результате получается клетка, содержащая гены своих родителей. Существуют три способа передачи генетической информации:
- конъюгация – прямая передача (не обмен) части ДНК при контакте от одной бактерии к другой (процесс идет только в одном направлении);
- трансдукция – перенос фрагмента ДНК с помощью бактериофага (вируса бактерий);
- трансформация – поглощение генетической информации отмерших или уничтоженных клеток из окружающей среды.
Таким образом, только в результате бинарного деления и почкования получаются идентичные друг другу клетки. При генетической рекомбинации клетка претерпевает изменения, вырабатывая новые свойства и получая другие функции.
Врачи отмечают, что размножение бактерий происходит путем деления, что является ключевым аспектом их жизнедеятельности. Этот процесс, известный как бинарное деление, позволяет микроорганизмам быстро увеличивать свою численность, что может иметь как положительные, так и отрицательные последствия для здоровья человека. В условиях благоприятной среды, таких как высокая температура и наличие питательных веществ, бактерии могут делиться каждые 20 минут, что приводит к экспоненциальному росту их популяции. Это объясняет, почему инфекции могут развиваться стремительно и вызывать серьезные заболевания. Врачи подчеркивают важность контроля за размножением бактерий, особенно в медицинских учреждениях, где инфекции могут угрожать пациентам с ослабленным иммунитетом. Понимание механизмов деления бактерий помогает в разработке эффективных методов лечения и профилактики инфекционных заболеваний.

Основные понятия
Для прокариотов понятия роста и развития почти тождественны. Под ними понимается то, что в процессе жизнедеятельности отдельный микроорганизм или группа бактерий синтезируют клеточный материал (белок, ДНК, РНК), за счет чего происходит увеличение цитоплазматической массы. Рост продолжается еще некоторое время, пока клетка не становится способной к размножению, и тогда развитие бактерий останавливается.
Размножение характеризуется способностью к самовоспроизведению. Результатом этого процесса является увеличение числа микроорганизмов на единицу объема, то есть происходит рост популяции.
Все вещества и структуры клетки могут расти и развиваться пропорционально. В этом случае микробиологи говорят о сбалансированном росте. Он таковым не является, если изменяются особенности среды. Тогда начинают преобладать определенные продукты метаболизма, а выработка других веществ прекращается. Зная о такой закономерности, ученые делают процесс роста намеренно несбалансированным, чтобы производить синтез полезных соединений.
Синдром избыточного бактериального роста
Не всегда рост бактериальных клеток приносит пользу, излишнее увеличение популяций бактерий в организме человека может быть опасным для здоровья. Нарушение качественного и количественного состава микрофлоры кишечника называют клиническим синдромом избыточного роста бактерий. Медики утверждают, что использовать для описания этого процесса термин «дисбактериоз» не совсем корректно. Дело в том, что количество полезных для организма анаэробных бактерий (бифидобактерии) действительно уменьшается, но число условно-патогенных клеток (например, аэробной кишечной палочки) увеличивается.
На разных участках желудочно-кишечного тракта обитают различные бактерии. В тонком кишечнике по мере продвижения постепенно меняется состав микрофлоры и количество микроорганизмов. Аэробные (растущие в кислородной среде) виды бактерий постепенно уступают место анаэробным (бескислородная среда). При клиническом синдроме избыточного роста бактериальный спектр смещается в сторону грамотрицательных (большинство патогенных), факультативно-аэробных и анаэробных организмов.
По мере приближения к толстой кишке увеличивается количество анаэробных бактерий (бифидобактерии и бактероиды). Основные представители анаэробной микрофлоры – бифидобактерии – отвечают за синтез белков, витаминов группы В, различных кислот и других необходимых для жизни веществ. Аэробные микроорганизмы (кишечная палочка) вырабатывают целый ряд витаминов и кислот, участвующих в пищеварении и поддерживающих иммунитет.
Молочнокислые бактерии – еще один представитель кишечной микрофлоры. Они относятся к микроаэрофильным организмам, т. е. одним из факторов роста и размножения молочнокислых бактерий является кислород, но в очень небольших количествах. Эти микроорганизмы отвечают за регулирование кислотности желудочно-кишечного тракта, благодаря чему тормозится рост гнилостных бактерий.
Каждый вид бактерий выполняет свою, четко обозначенную функцию. При синдроме избыточного роста фекальная микрофлора, в нормальных условиях обитающая в толстом кишечнике (кишечная палочка или анаэробные клетки), попадает в тонкую кишку. Меняется количественный и качественный состав бактериальной микрофлоры, выполнение некоторых функций замедляется или становится невозможным. Появляются условия для роста и размножения патогенных бактерий.
Размножение бактерий — это удивительный процесс, который происходит с поразительной скоростью. Многие люди не осознают, что бактерии могут делиться каждые 20-30 минут в идеальных условиях. Это означает, что одна бактерия может превратиться в миллионы всего за несколько часов. Такой быстрый рост позволяет им адаптироваться к изменениям в окружающей среде и выживать в самых неблагоприятных условиях. Однако, несмотря на свою простоту, процесс деления бактерий является высокоорганизованным и контролируемым. Он включает в себя репликацию ДНК и разделение клеточной стенки, что обеспечивает точность и стабильность потомства. Это удивительное свойство делает бактерии не только одними из самых древних организмов на Земле, но и важными участниками экосистемы, играющими ключевую роль в круговороте веществ.

Генетический аппарат
За систематику микроорганизмов, их специфичность как вида, функции отвечают гены. В клетках прокариотов гены располагаются в хромосоме, единственной замкнутой молекуле ДНК. Благодаря специфическому строению бактерий в их клетке сопряжены процессы трансляции и транскрипции. МРНК, которая только синтезировалась, сразу же связывается с рибосомами, так как область, где располагается хромосома, не окружена мембраной.
Носителем генетической информации являются также плазмиды. Это замкнутая в кольцо ДНК, содержащая гены, которые проявляются только в специфических условиях.
Бактерии отличаются от других организмов особенностями строения, размножения, жизнедеятельности. Именно от этого зависит, к какому виду и ряду они будут относиться. Знания из микробиологии необходимы также для того, чтобы иметь возможность определить заболевание, так как есть ряд бактерий, которые вызывают их развитие. Изучение одноклеточных микроорганизмов необходимо, так как их значение в природе и жизни человека невозможно переоценить. Существует очень большое количество разнообразных микроорганизмов, но все они имеют свои отличия и характерные признаки.
Что происходит с микроорганизмами во время бактерицидной фазы?
Если бактерии при идеальных условиях способны очень быстро развиваться, то почему, например, в только что полученном молоке их рост некоторое время не происходит? Среда достаточно благоприятная, и даже асептические условия доения не исключают наличие большого числа микроорганизмов. Но в свежем молоке имеются лактенины – бактерицидные вещества, способные определенный период времени сдерживать развитие бактерий.
Действие лактенинов настолько сильно, что многие микроорганизмы не просто замедляют рост, но и погибают. Период их действия, названный бактерицидной фазой, постепенно заканчивается. Это зависит от начального количества бактерий в молоке и повышения температуры продукта. Влияние лактенинов может продолжаться от 2 до 40 часов. Бактерицидную фазу стараются продлить и молоко охлаждают. По ее истечении рост микробов и бактерий возобновляется.
Даже если изначально в молоке было небольшое количество молочнокислых микроорганизмов, то они постепенно начинают преобладать. И для того чтобы предотвратить скисание и избавиться от вредных бактерий, применяют тепловые способы обработки. Нагрев, кипячение и другие виды тепловой обработки относят к еще одному способу устранения нежелательной микрофлоры в продуктах. И можно назвать еще одну важную составляющую среды, оказывающую влияние на рост и развитие бактерий, – температуру.

Особенности дыхания клетки
Кислород микроорганизмы воспринимают по-разному:
- анаэробы прекрасно обходятся без воздуха;
- для строгих или облигатных анаэробов наличие молекулярного кислорода недопустимо;
- аэробы живут только в кислородсодержащей среде.
Принцип дыхания бактерий прямо противоположен нашему. Человек извлекает энергию из еды и направляет ее на поддержание жизнедеятельности. Бактерии, напротив, берут энергию в процессе дыхания при биологическом окислении и применяют ее для обмена веществ.
Микроорганизмам нужны разные условия для выживания:
- строгим аэробам необходимо 20% кислорода;
- микроаэрофилы довольствуются меньшим процентом, но кислород им все равно необходим;
- факультативные анаэробные, к которым относится большинство болезнетворных микробов, спокойно существуют в кислородосодержащей среде и бескислородной, меняя типы дыхания;
- для строгих анаэробов наличие свободного кислорода совершенно недопустимо.
Процесс брожения или разложение органики анаэробами сопровождается выбросом энергии. В биотехнологиях широко используются многие виды брожения: спиртовое, молочнокислое, масляно-кислое и т. д. Кстати, выделение тепла при гниении торфа, сена или хлопка иногда приводит к пожарам. Именно этим объясняется, почему торфяники могут самовозгораться в жаркий период.
Фазы развития бактериальной популяции
При посевах на питательную среду развитие бактериальной популяции проходит несколько фаз.
Фаза задержки размножения
Это фаза интенсивного роста бактерий. Ее длительность составляет около 2-х часов. Она зависит от возраста культуры, периода приспособления, качества питательной среды и др.
Логарифмическая фаза
В эту фазу отмечается пик скорости размножения и увеличения бактериальной популяции. Ее длительность составляет 5 — 6 часов.
Фаза отрицательного ускорения
В эту фазу отмечается спад скорости размножения, уменьшается количество делящихся и увеличивается число погибших бактерий. Причина отрицательного ускорения — истощение питательной среды. Ее длительность составляет около 2-х часов.
Стационарная фаза максимума
В стационарную фазу отмечается равное количество погибших и вновь образованных особей. Ее длительность составляет около 2-х часов.
Фаза уменьшения скорости отмирания
В эту фазу оставшиеся живыми клетки бактерий переходят в состояние покоя.
Рис. 18. На рисунке отображена кривая роста бактериальной популяции.
Рис. 19. На фото колонии синегнойной палочки сине-зеленого цвета, колонии микрококков желтого цвета, колонии Bacterium prodigiosum кроваво-красного цвета и колонии Bacteroides niger черного цвета.
Рис. 20. На фото колонии бактерий. Каждая колония — потомство одной-единственной клетки. В колонии число клеток исчисляется миллионами. вырастает колония за 1 — 3 суток.
Особенности внутреннего строения
Теперь необходимо рассказать об основных особенностях строения бактериальной клетки. Внутри она заполнена цитоплазмой. Эта полужидкая субстанция содержит в себе различные ферменты, а также дополнительные вещества, необходимые для жизнедеятельности микроорганизмов. Клетки любых бактерий лишены ядра. Основная генетическая информация находится в центре клетки. Это главные особенности строения клетки такого микроба.
Также в состав цитоплазмы входят другие запасные питательные вещества – полисахариды, гликоген, полифосфаты. Эти «запасы» данные микробы расходуют в процессе питания или при передвижениях.
Таковы основные особенности строения и жизнедеятельности бактерий. Но необходимо напомнить и некоторые другие основные интересные детали, связанные с этой большой группой микроорганизмов.
Условно-патогенные микроорганизмы, присутствующие на коже
Наличие разных видов одноклеточных на коже – это нормальное явление, причем они могут быть различных разновидностей. Однако при наступлении определенных условий, которые стимулируют размножение бактерий и грибов, здоровье может быть серьезно подорвано. Чтобы этого избежать, необходимо исключить получение микробами избыточного питания. Для этого достаточно соблюдать элементарные правила личной гигиены и придерживаться здорового питания.
На коже всегда присутствуют болезнетворные бактерии – стрептококки и стафилококки, которые способны снизить иммунитет, вызывая инфекционные заболевания и провоцируя возникновение поражений.
Отдельное внимание стоит уделить разнообразным грибам, обитающим в складках кожи и около волосяных луковиц. Большинство болезней кожи вызываются дерматофитами, дрожжевыми и плесневыми грибами
Дерматофиты используют для своего питания кератин, содержащийся в коже и волосах
Очень важно не допускать контакта с поверхностью, которая заражена этим грибом. Таким простым способом можно снизить риск возникновения заболевания
Грибы кандида могут с легкостью попасть на кожу из окружающей среды. Чтобы они смогли развиваться, достаточно сниженного иммунитета. В результате возникает кандидоз.
Кроме того, грибки можно называть первопричиной появления таких заболеваний, как лишай и себорейный дерматит.
«Цветение» пресной воды из-за цианобактерий
Условия выращивания микробов в искусственных средах
Для изучения (медицина, микробиология) и использования (промышленность) выращивают бактериальные культуры на искусственных питательных средах, которые разделяются по консистенции, происхождению и назначению:
- жидкие, полужидкие и плотные (твердые) искусственные среды;
- среды животного, растительного происхождения или синтетические (химически чистые соединения в строго определенной концентрации);
- обычные (универсальные), дифференциальные (различаются по видам бактерий), специальные, избирательные или среды обогащения (подавляющие рост нежелательных микробов).
Существуют бактерии, которым требуются особые условия. Например, анаэробные микроорганизмы (как спорообразующие, так и не спорообразующие) культивируют в анаэробных условиях (без кислорода). Для аэробных клеток решающим фактором размножения становится кислород. Факультативные анаэробы способны менять способ дыхания в зависимости от условий. Спорообразующие аэробные организмы, используемые для получения пробиотиков, очень чувствительны к уменьшению питания и его качеству. Спорообразующие анаэробы требуют полного отсутствия кислорода. Основной принцип культивирования микроорганизмов – создание благоприятных условий (питание, дыхание, температура), что иногда представляет определенные трудности.
Так, для выращивания анаэробов применяют метод глубокого посева, т. е. культуру бактерий вносят в глубину плотной питательной среды, добавляют в атмосферу роста химические вещества, поглощающие кислород, или откачивают воздух, замещая его инертным газом. В случае со спорообразующими бактериями используют внесение в питательную среду ингибитора белкового синтеза, тем самым останавливая процесс спорообразования.
Ферменты бактерий
Все биохимические процессы в бактериальной клетке протекают при помощи ферментов — биологических катализаторов химических реакций в живой системе. Их действие направлено только на одно вещество. Ферменты специфичны для каждого вида бактерий. По наличию определенных ферментов проводится идентификация микроорганизмов.
- Ферменты бактериальной клетки состоят из 2-х частей — белковой и небелковой (простетической). Белковая часть состоит из простых белков. В небелковую часть входят такие микроэлементы, как железо, медь, кобальт, цинк, витамины и их производные.
- В зависимости от вида катализирующих особенностей ферменты подразделяются на 6 групп: оксидоредуктазы, трансферазы, гидролазы, лиазы, изомеразы и лигазы.
- Лигазы и рестриктазы широко применяются в биотехнологии (генетическая инженерия, фармацевтическая, легкая и пищевая промышленность).
- Ферменты в бактериальной клетке распределены не хаотично, а строго упорядоченно.
- Ферменты, отвечающие за энергетический обмен и транспортировку питательных веществ, находятся в цитоплазме клеток.
- Ферменты, принимающие участие в белковом синтезе, имеют связь с рибосомами. Ряд ферментов находятся в цитоплазме хаотично.
- Эндоферменты функционируют внутри бактериальной клетки. Они ускоряют реакции биосинтеза и катаболизма. Экзоферменты выделяются клеткой наружу, где происходит расщепление питательных веществ на более простые.
- Гидролитические ферменты участвуют в расщеплении макромолекул. Субстратом для них служат различные сахара.
- Протеолитические ферменты расщепляют белки.
- Патогенные бактерии выделяют ферменты, разрушающие ткани организма человека, животного или растений. Например, стафилококки выделяют плазмокоагулазу — главного фактора патогенности микроба.
Рис. 13. Способность уксусных палочек окислять этиловый спирт до уксусной кислоты используется сегодня для получения уксуса, применяемого в пищевых целях и при заготовке кормов для животных — силосовании (консервировании). На фото процесс силосования кормов. Силос — сочный корм, обладающий высокой кормовой ценностью.
Рис. 14. На фото колонии бактерий, которые растут и размножаются на капле нефти. Они вырабатывают поверхностно-активные вещества, отчего нефтяная пленка расползается (убегает). Широко применяется деятельность ксенобактерий для очистки почв и водоемов, загрязненных нефтепродуктами.
Способы получения энергии
Бактерии способны получать энергию как из органических, так и из неорганических веществ. Процесс получения питания идет по всей поверхности микроорганизма. Скорость метаболизма и размножения прокариот очень высока, в особенности в комфортных условиях. Например, обычные дрожжи, если их не ограничивать, за сутки могут увеличить свою массу в 50 тысяч раз.
Кстати, помимо применения в пищевой промышленности, дрожжи применяют в биотехнологии для производства ксилита (заменитель сахара), ферментов, пищевых добавок и даже для очистки водоемов от нефтяных пятен.
В зависимости от типа питания микробы делятся на:
- Автотрофы («самопитающиеся») – клетки, вырабатывающие органические соединения из неоргаников. По энергии, применяемой для обмена веществ, их можно разделить на:
- фототрофы – бактерии, живущие за счет солнечной энергии (фотосинтез);
- хемотрофы – организмы, получающие энергию от химических реакций окисления, это нитрифицирующие бактерии, серобактерии, железобактерии и др.
2. Гетеротрофы («иная пища») – организмы, использующие готовые органические вещества. По используемым источникам пищи их разделяют на:
- сапрофиты разлагают отмершие органические остатки;
- паразиты получают питательные компоненты из живых клеток.
Фототрофы и хемотрофы, с помощью энергии солнца и неорганических веществ, создают строительный материал для органических соединений. Паразиты существуют и размножаются на живых клетках, это патогенные и условно-патогенные бактерии. Именно они провоцируют болезни.
В природе сапрофиты разлагают отмершие органические фрагменты с помощью сапротрофного питания на неорганические и простейшие органические соединения. Именно сапрофиты замыкают круг, возвращая в природу питательные компоненты, годные для дальнейшего использования иными организмами.
В последнее время для характеристики типов питания все чаще используют новые термины «органотрофы» и «литотрофы», и вот почему:
- органотрофы – бактерии, использующие органические вещества;
- литотрофы (греч. «литос» – камень) – микроорганизмы, живущие на минеральных средах.
Однако четко разделить бактерии по особенностям питания довольно сложно – некоторые микробы легко изменяют способ получения энергии, приспосабливаясь к природе окружающей среды.
Одно из главных условий для размножения бактерий – определенные ферменты, называемые факторами роста. Начало деления клетки происходит под действием особого ферментативного аппарата (отрезка ДНК), содержащего информацию об удвоении генома. Однако самостоятельно синтезировать ферменты они не могут. Вот почему бактериям необходимы готовые соединения (витамины, аминокислоты для синтеза белка) и прочие вещества. Эту особенность бактерий широко применяют в биохимических технологиях, регулируя их прирост.
Дыхание бактерий
При окислении веществ органической или неорганической природы высвобождается энергия, так необходимая для бактериальной клетки. Она идет на образование молекул АТФ — источника энергии. Для использования энергии химических реакций большинство бактерий использует кислород. Этот процесс называется дыханием.
Аэробные бактерии (аэробы)
Аэробы развиваются в средах, содержащих кислород.
- Облигатные аэробы развиваются только при наличии достаточного количества кислорода в окружающей среде. Такой тип дыхания характерен для бактерий, обитающих в почве, в водной среде, в воздухе. Их дыхание осуществляется через окисление сероводорода, метана, водорода, железа и азота (Sulfomonas denitrificans, Вас. methanicus, Вас. hydrogenes, Ferri bacterium и Nitrosomonas, Nitrobacter). Бактерии этой группы принимают активное участие в круговороте веществ в природе. В наличии кислорода нуждаются патогенные бактерии из рода Bacillus, Bacterium, Bordetella, Brucella, Corynebacterium, Diplococcus, Pasteurella и др. В повышенном содержании кислорода нуждаются микобактерии туберкулеза, туляремии и холеры.
- Факультативные бактерии способны развиваться при наличии в окружающей среде минимального количества кислорода — Salmonella, Shigella, Escherichia и др.
Рис. 8. На фото аммонифицирующие бактерии подвергают останки погибших животных и растений разложению.
Рис. 9. Разлагают клетчатку целлюлозные бактерии. В результате их работы почва обогащается гумусом, что значительно повышает ее плодородие, а углекислота возвращается в атмосферу. Зеленым цветом окрашены внутриклеточные симбионты, желтым – масса перерабатываемой древесины.
Анаэробные бактерии (анаэробы)
Анаэробы развиваются без доступа кислорода, разлагая органические соединения в бескислородной среде. Свободный кислород подавляет активность ферментов этих бактериальных клеток. Бактерии этого типа обитают в компостных кучах, ранах больного человека, кишечном тракте людей и животных.
- Облигатные анаэробы не развиваются при наличии кислорода в окружающей среде (бактерии рода Clostridium, бактерии, вызывающие молочнокислое и маслянокислое брожение).
- Факультативные анаэробы развиваются в присутствии кислорода или без него (кокки).
- При небольшом количестве кислорода могут развиваться микроаэрофиллы Clostridium histolyticum, Clostridium tertium и др.
Рис. 10. На фото газовая гангрена. Заболевание вызывается анаэробными бактериями рода клостридиум.
Рис. 11. На фото сибирская язва. Заболевание вызывается анаэробными бактериями рода бациллюс.
Рис. 12. Биоспорин-Биофарма — отечественный препарат, содержащий апатогенные бактерии рода Bacillus. Споры Bacillus выделяют противомикробные вещества, способные подавлять рост целого ряда условно-патогенных бактерий, не влияя при этом на нормальную микрофлору кишечника.
Внутренний состав одноклеточных
Составляющие клетки:
- Капсула (ее внешняя оболочка) – слизь, которая защищает клетки от повреждений, высыхания, хранит в себе резервные вещества.
- Клеточная стенка – поддерживает форму клеток, выполняет защитную функцию и транспортировку веществ.
- Клеточная мембрана – выполняет транспортную функцию.
- Цитоплазма – обеспечивает связь между органеллами (различными участками клетки).
- Нуклеотид – генетический банк.
- Жгутики (их может не быть) – отвечают за передвижение клеток.
Простота строения тела не мешает бактерии совершать довольно сложные действия: передвигаться, улавливать запахи, убегать от опасности. Многообразие одноклеточных насчитывает более миллиона наименований. Они невероятно жизнеспособны, выживают при очень высоких температурах и небольшом холоде. Основные формы тела бактерии определяют ее жизнедеятельность – возможность перемещаться, питаться, размножаться и защищаться. И, похоже, являются оптимальными, ведь они пережили динозавров, а это что-то значит!
Вопрос-ответ
Как быстро размножаются бактерии?
При благоприятных условиях количество бактерий в продукте может удваиваться каждые 20—30 минут. Логарифмического роста, фаза стационарного роста и фаза гибели. Быстрее всего бактерии размножаются на фазе логарифмического роста.
Как быстро у многих бактерий может происходить деление?
Содержимое клетки разделяется перетяжкой пополам и образуются две дочерние клетки. Они растут и опять делятся. Бактерии размножаются быстро. Если условия благоприятны, то процесс деления происходит каждые (20)–(30) мин.
Как называется способ размножения бактерий?
Бактерии, как и прочие прокариоты, размножаются бесполым путем. Установлено несколько способов размножения: Поперечное деление (бинарное деление) – основной способ размножения бактериальных клеток, путем простого деления клетки пополам.
Как быстро растут бактерии?
МИКРОБЫ РАЗМНОЖАЮТСЯ в благоприятных условиях окружающей среды очень быстро, увеличиваясь в количестве до 6 раз в час, т. Е. Они делятся пополам через каждые 10-20 минут.
Советы
СОВЕТ №1
Изучите основы размножения бактерий, чтобы лучше понять, как они влияют на окружающую среду и здоровье человека. Знание о том, как быстро они делятся, поможет вам осознать важность гигиенических мер для предотвращения инфекций.
СОВЕТ №2
Регулярно мойте руки с мылом, особенно перед едой и после посещения туалета. Это поможет снизить риск передачи бактерий и предотвратить распространение инфекций.
СОВЕТ №3
Используйте антисептики и дезинфицирующие средства для обработки поверхностей в вашем доме, особенно в местах, где могут скапливаться бактерии, таких как кухня и ванная комната.
СОВЕТ №4
Обратите внимание на хранение продуктов. Правильные условия хранения (температура, упаковка) помогут замедлить размножение бактерий и сохранить продукты свежими и безопасными для употребления.






















![Глава 4. физиология микроорганизмов [1986 черкес ф.к., богоявленская л.б., бельская н.а. - микробиология]](https://medlari.ru/articles/wp-content/uploads/2024/12/1f2427e2976b37cb8e1a5bded5766f4d.jpg)

![Глава 4. физиология микроорганизмов [1986 черкес ф.к., богоявленская л.б., бельская н.а. - микробиология]](https://medlari.ru/articles/wp-content/uploads/2024/12/ce207556d16bfddbebea4acb672967c1.jpg)














![Глава 4. физиология микроорганизмов [1986 черкес ф.к., богоявленская л.б., бельская н.а. - микробиология]](https://medlari.ru/articles/wp-content/uploads/2024/12/715bbd5d1c48c0f0761437d3d92a640c.jpg)








